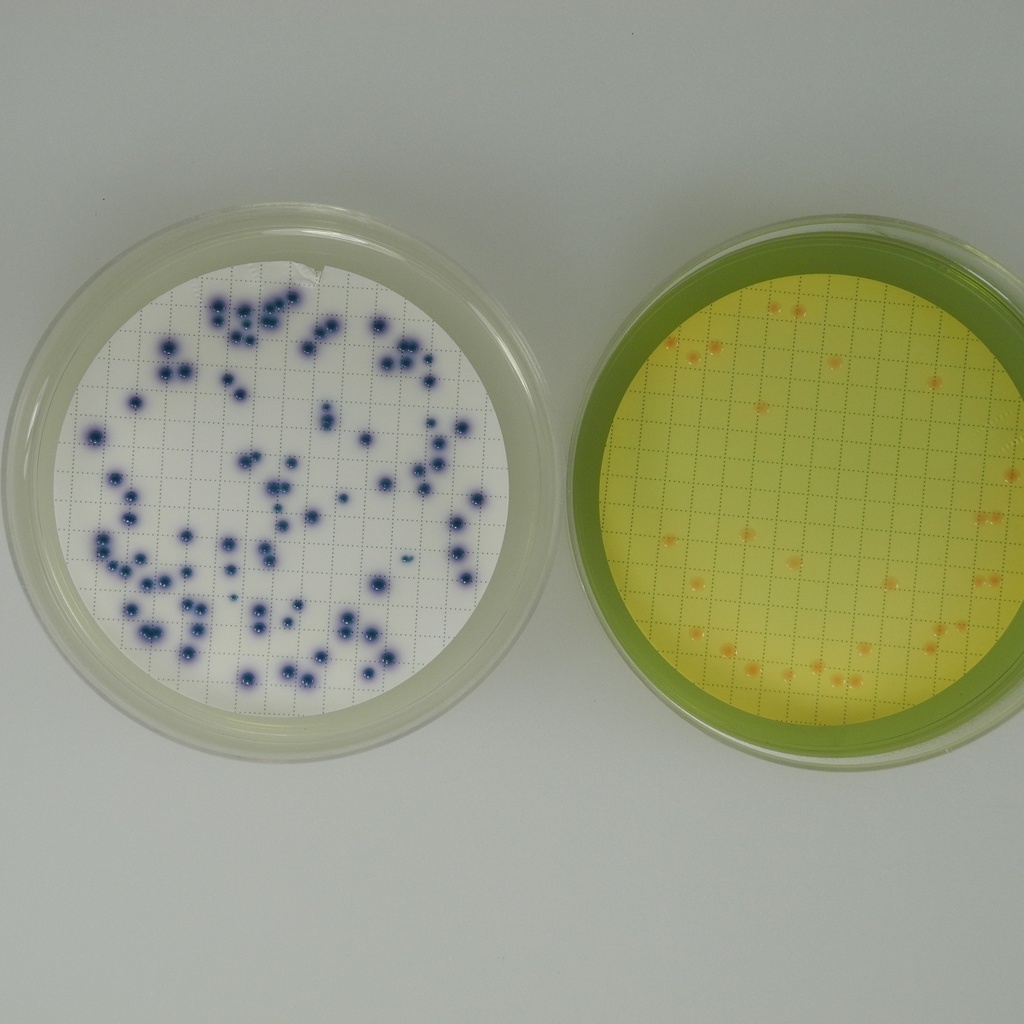
Liofilchem® Chromatic™ Coliform Agar ISO

Liofilchem® Chromatic™ Coliform Agar ISO
Catalog No :
CAS Number :
Brand :
In Stock
Chromogenic Medium for Detection and Enumeration of Escherichia coli and Coliform Bacteria in Water According to ISO 9308-1
Specifications:
| Application | Water Quality Analysis, Industrial Microbiology | ||
| Storage Temperature | Ambient | ||
| Product Type | Culture Medium | Forms | Powder, Solid |
| Product Brand | Liofilchem | ||
| Product Grade | Microbiology grade | ||
Liofilchem® Chromatic™ Coliform Agar ISO is a selective and differential chromogenic medium designed for the detection and enumeration of Escherichia coli and coliform bacteria in water samples with low background flora, following the ISO 9308-1:2014 membrane filtration method.
This medium enables simultaneous detection and differentiation of E. coli and coliforms through distinct chromogenic reactions based on enzyme activity (β-D-galactosidase and β-D-glucuronidase). When used with Tergitol 1.5% Supplement (ref. 80042), it effectively inhibits Gram-positive flora, improving selectivity and accuracy.
Key Features
- ISO 9308-1 compliant for enumeration of E. coli and coliforms in water.
- Dual chromogenic system for visual differentiation of E. coli (dark-blue to violet) and coliforms (pink to red).
- Compatible with membrane filtration, spread plating, or direct streaking.
- Contains sodium pyruvate to enhance recovery of stressed or injured bacteria.
- Supports oxidase testing and indole confirmation on same plate.
- Tergitol supplement ensures strong selectivity by inhibiting Gram-positive organisms.
- Rapid results within 18–24 hours under aerobic incubation.
Typical Formula (per litre)
| Component | Concentration (g/L) |
|---|---|
| Enzymatic Digest of Casein | 1.0 |
| Yeast Extract | 2.0 |
| Sodium Chloride | 5.0 |
| Sodium Dihydrogen Phosphate | 2.2 |
| Disodium Hydrogen Phosphate | 2.7 |
| Sodium Pyruvate | 1.0 |
| Sorbitol | 1.0 |
| Tryptophan | 1.0 |
| Salmon®-GAL | 0.2 |
| X-Glucuronide | 0.1 |
| IPTG | 0.1 |
| Agar | 15.0 |
| Final pH (25°C) | 6.8 ± 0.2 |
Principle of the Method
- Chromogenic substrates (Salmon®-GAL and X-Glucuronide) detect β-D-galactosidase (coliforms) and β-D-glucuronidase (E. coli) activity, generating distinct colony colors.
- Tryptophan allows performance of the indole test for E. coli confirmation.
- Phosphates act as pH buffers to maintain stability.
- Sodium pyruvate enhances recovery of injured bacteria, while Tergitol 1.5% Supplement improves selectivity.
- Sorbitol acts as a carbon source.
- Agar provides the solid matrix for colony formation and visualization.
Preparation
- Suspend 31.3 g of powder in 1 L of deionized or distilled water.
- Add 10 mL of Tergitol 1.5% Supplement (ref. 80042).
- Heat to boil with frequent mixing until completely dissolved.
- Do not autoclave.
- Cool to 45–50°C and pour aseptically into Petri dishes.
Technique
- Filter water samples through a 0.45 µm membrane filter.
- Place the filter onto the surface of Chromatic™ Coliform Agar ISO.
- Incubate aerobically at 36 ± 2°C for 18–24 hours.
- Alternatively, use direct streaking, spread plating, or pour plating methods.
-
Observe colony colors for identification:
- E. coli → Dark-blue to violet colonies
- Other coliforms → Pink to red colonies
- Other bacteria → Colorless colonies
Interpretation of Results
| Microorganism | Colony Color | Notes |
|---|---|---|
| Escherichia coli | Dark-blue to violet | β-glucuronidase and β-galactosidase positive |
| Enterobacter/Klebsiella spp. | Pink to red | β-galactosidase positive only |
| E. coli O157 (β-glucuronidase negative) | Pink to red | Confirm with oxidase test |
| Shigella/Salmonella spp. (some strains) | Light blue | β-glucuronidase positive |
| Other bacteria | Colorless | Non-coliforms |
Quality Control
| Microorganism | WDCM/ATCC No. | Growth | Colony Color |
|---|---|---|---|
| Escherichia coli | WDCM 00013 | Good | Dark-blue to violet |
| Enterobacter aerogenes | WDCM 00175 | Good | Pink to red |
| Enterococcus faecalis | WDCM 00009 | Inhibited | — |
| Pseudomonas aeruginosa | WDCM 00024 | Good | Colorless |
Incubation: 18–24 h at 36 ± 2°C (aerobic).
Appearance (Dehydrated Medium): light beige, homogeneous powder.
Appearance (Prepared Medium): slightly opalescent, light amber.
Storage and Stability
- Store dehydrated medium at 10–30°C in a dry, tightly sealed container.
- Store prepared plates at 2–8°C, protected from light.
- Shelf life: 2 years for dehydrated medium; 4–6 months for ready-to-use plates.
Safety and Handling
- For in vitro diagnostic use only.
- Use by trained personnel in microbiology laboratories.
- Handle biological samples under biosafety level 2 precautions.
- Dispose of used media per local environmental and biosafety regulations.
Ordering Information
| Product Description | Ref. Code | Format | Packaging |
|---|---|---|---|
| Chromatic™ Coliform Agar ISO 90 mm Plates | 11630 | Ready-to-use | 20 Plates |
| Chromatic™ Coliform Agar ISO 60 mm Plates | 163852 | Ready-to-use | 20 Plates |
| Chromatic™ Coliform Agar ISO 60 mm Plates (Bulk) | 173852 | Ready-to-use | 450 Plates |
| Chromatic™ Coliform Agar ISO Contact Plates | 15346 | RODAC Format | 20 Plates |
| Chromatic™ Coliform Agar ISO Bottles | 481190 | Melt-and-Pour | 6 × 100 mL Bottles |
| Chromatic™ Coliform Agar ISO Dehydrated Medium | 610630 | Powder | 500 g Bottle |
| Chromatic™ Coliform Agar ISO Dehydrated Medium | 620630 | Powder | 100 g Bottle |
Liofilchem® Chromatic™ Coliform Agar ISO provides a reliable, ISO 9308-1–compliant chromogenic solution for the detection and enumeration of E. coli and coliforms in water samples with low background flora. With its dual enzyme detection system, simple workflow, and compatibility with membrane filtration or direct inoculation methods, it is ideal for environmental, food safety, and public health microbiology laboratories requiring rapid and standardized microbial testing.
- Format & pack size: 60 mm Plates, 450/case Powdered Dehydrated Medium, 100g Powdered Dehydrated Medium, 500g Broth, 6 × 100 mL Bottles 60 mm Plates, 20/box 90 mm Plates, 20/box




 0
0